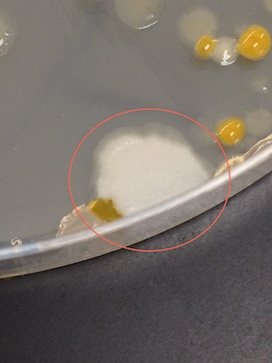

User:Shauna McManus/Notebook/Biology 210 at AU
Zebrafish Analysis
03/06/2015
Purpose:
Rhodamine 6G, which is also known as Rhodamine 590, is a fluorescent dye that is commonly used in commercial lasers and in fluid mechanics as a tracer or marker for laser-induced fluorescence, or LIF (Zehentbauer et al., 2014). It can also be found in the wastewater from colorant manufacturing industries such as textile industries, paper mills, and leather industries (Raschitor, Fernandez, Cretescu, Rodrigo, Cañizares, 2014). This dye-containing wastewater, as well as the water to which dye has been deliberately added, can potentially present serious problems to our water environment. Although there has not been a large amount of research on this matter, it is known that various dyes like Rhodamine 6G that end up in the water supply may contain chemicals that are toxic, carcinogenic, or mutagenic, for various aquatic organisms (Raschitor, Fernandez, Cretescu, Rodrigo, Cañizares, 2014).
In order to determine the effects of Rhodamine 6G on vertebrates, the development of zebrafish, a model vertebrate, will be observed in a control solution and in a test solution. Observation will begin while the zebrafish are in embryo. The zebrafish embryos will be randomly allocated to either the control, which will be pure water, or the treatment, which will be a diluted Rhodamine 6g solution. The fish will be observed three times a week in regular intervals for 2 weeks. At each observation careful measurements will be taken so that differences in developmental growth can be observed between the test and the control. The goal of observing the zebrafish development over a period of two weeks is to demonstrate the effects that exposure to Rhodamine 6G can have on vertebrate development. Based on the published information about Rhodamine 6G, it can be hypothesized that the addition of Rhodamine 6G to water will have adverse effect on vertebrate development. If the zebrafish are exposed to Rhodamine 6G then their embryonic development will be stunted in comparison to a control.
Methods and Materials:
On day 1, a Wednesday, a control group and a test group were established. For the control group 20 mL of Deerpark water was added to a labeled Petri dish. 20 healthy translucent embryos were then added to the control. For the test, Rhodamine 6G in a 100x fold concentration was diluted to make a 1x fold concentration. This was done by adding 200 µl of Rhodamine 6G into 188 mLs of Deerpark water in a conical tube. The contents of the tube were then added to a second labeled petri dish. Again, 20 healthy translucent embryos were added. The developmental stage of the embryos was observed and recorded.
Every Friday, Monday, and Wednesday for 2 weeks, observations of the development of the zebrafish were recorded. The developmental stage, fish length, tail length, eye diameter, heartbeat, and fin development were recorded. The eyes are oval shaped rather than circular, so when the eye diameter was measured the shorter distance across rather than the longer distance was recorded. Each time that observations were made any dead fish, empty egg cases or other contaminants were removed from the water or test solution. 15 mL of the water and test solution were removed with a pipette each observation day and were replaced with 25 mL of fresh water or test solution respectively. More was added than was removed to account for evaporation between observation days.
On Day 6 one drop of Paramecium food was added to each Petri dish. On Day 8 one fish from the control group and one fish from the test groups were fixed. The fish were picked up with a dropper from their respective Petri dish and then added to separate tubes. 1 drop of Tricaine solution per mL of water that was sucked up with the fish was then added to the tube. Paraformaldehyde was added by a TA and the samples were stored.
On the final day of the experiment the fixed samples were examined. The same observations that were recorded on the previous days were again recorded for the fixed samples.
Data and Observations:
On Day 3 the majority of the control embryos and about half of the test embryos were dead (Table 1). As a result several adjustments to the experimental design were made. All embryos in the control were removed and a new control was created following the same procedure as the first control. The 11 dead embryos in the test were removed, but rather than replacing the remaining 9 embryos a second test was formed. The same amount and concentration of the Rhodamine 6G was added to the new test and 11 new embryos were added.This made it so that the start date for Test 2 was the same as the start date for the new control.
On Day 6 of the experiment, the second observation day there were some hatched fish in the control and both tests (Table 2). There were one dead fish in Test 1 that was removed. More development was evident and heart beats could be observed. The fish in both Test 1 and Test 2 showed several developmental differences from the fish in the control. They were lighter in coloration and would spin around in rapid but stationary circles.
The fish continued to grow bigger and development became more pronounced as time went on. Around day 8 it became hard to see the heart beat because the fish were less transparent and the darker coloration and larger size obscured the heart (Table 3). It was possible to observe traces of the neon Rhodamine dye in the bloodstream of the test fish. The test fish also has slower fin development and continued to be lighter in color. The control fish swam in smooth, controlled motion while the test fish would swim around jerkily with thrashing tails.
By day 10 the developmental difference between control and tests were more pronounced. Although the overall growth in terms of length was similar the fin development was clearly delayed and under-developed in the tests (Table 4). At this point it was also possible to see even without a microscope that the tails of several fish in Test 1 and Test 2 were crooked and deformed (Figure 1).
On day 13 there was still not any obvious differentiation in growth in terms of length but there were still pronounced behavioral differences between the control and Test 1 and Test 2 (Table 5). The eyes of the control fish showed clear development. It was possible to see a difference between the dark pupil and the surrounding eye. However the eyes of the fish in both of the Test solutions were entirely dark and the fish kept swimming into the walls of the dish. The fish in Test 1 and Test 2 no longer moved around as much but would randomly spasm and move jerkily for a few moments. The crookedness of the tails of the fish in both Test 1 and Test 2 were even more pronounced (Figure 2).
A small change was also made to the experimental procedure. There was not any research as to what concentrations of Rhodamine 6G are present in the water supply, so in order to see the effects of a higher concentration we made a third test. We put 25 mL of the 100x fold concentration Rhodamine 6G into a Petri dish and then 2 fish from Test 1 and 2 fish from Test 2 were transferred to the new Test 3 dish.
On the final day of observation the 4 fish that were added to Test 3 were completely deformed and mutated after only 2 days in the 100x fold concentration of Rhodamine 6G. Their fins were crumpled and deformed, and their eyes were two different sizes (Figure 3). All of the fish in the Test 3 dish were completely dead, as were all of the fish in Test 1 and one of the fish in Test 2. The dead fish in Test 1 appeared to be being eaten by the remaining Paramecium protists and had black matter coming out of their eyes.
Also on the final day the two fixed specimens were re-examined. Unfortunately, it appeared that only the Tricaine had been added to the samples and that the Paraformaldehyde had not been added by the TA that was filling in on day 6. As a result, the two samples were severely degraded and eroded and it was not possible to make any observations on either of the samples that should have been fixed.
Conclusions:
Although it did not appear the the Rhodamine influenced the rate of growth in the zebrafish it clearly had strong effects on the development of certain features and on the behavioral development of the fish. The death of the control fish and many of the test fish after 2 days seems to have been through the collection of possibly moldy embryos, and does not appear to be related to the experimental treatments. The severity of the developmental and behavioral effects was correlated with the concentration of the Rhodamine 6G, with the growth deformities increasing in severity as the concentration of Rhodamine 6G increased. The fish that were exposed to the Rhodamine had abnormally developed and deformed fins and tails. One of the most startling developmental deformities though was in the eyes. By week 13 it was possible to differentiate between the dark pupils and the rest of the surrounding eye in the control fish. This distinction was never apparent in any of the different test fish. Instead the eyes of the test fish always remained completely black and the fish would keep swimming into the walls over and over as if they were possibly blind.The test fish also exhibited various abnormal behaviors, including random spinning, moving jerkily, thrashing their tails and shaking spasms. None of these behaviors were observed in the control fish. It is not known at what concentration Rhodamine 6G ends up in the water supply, so the fact that the severity of the effects (with the ultimate effect being death) were influenced by the magnitude as well as the duration of the concentration is important to further regulation of the amount of Rhodamine 6G that can be used as a tracer dye. It can also influence regulations on wastewater from industries that use Rhodamine 6G in manufacturing. It would be beneficial to do a further study analyzing the effects of a broader range of Rhodamine concentrations in order to determine if there is a relatively safe concentration so that the beneficial properties of Rhodamine 6G can still be utilized. However, at the concentrations that we observed, it was very evident that the addition of Rhodamine 6G to the water had an adverse effect on vertebrate development, thus proving our hypothesis correct.
Sources:
Raschitor, A., Fernandez, C. M., Cretescu, I., Rodrigo, M. A., Cañizares, P. (2014). Sono-Electrocoagulation of Wastewater Polluted with Rhodamine 6G. Separation and Purification Technology. 135, 110-116.
Zehentbauer, F. M., Moretto, C., Stephen, R., Thevar, T., Gilchrist, J. R., Pokrajac, D., Richard, K. L. & Kiefer, J. (2014). Fluorescence spectroscopy of Rhodamine 6G: Concentration and Solvent Effects. Spectrochimica Acta Part A: Molecular and Biomolecular Spectroscopy, 121, 147-151.
-SM
16S Sequence Analysis
02/26/2015
Purpose:
During week 3 we categorized different bacterial species that were found growing on our nutrient agar and nutrient agar plus tetracycline plates. We examined the morphological characteristics of the bacterial colonies, examined the cells as wet mount slides under microscopes, and performed gram stains. However, another way to identify bacterial species more specifically is to perform a PCR amplification. PCR amplifications use the natural ability of DNA or RNA polymerase to synthesize and sequence new DNA or RNA strands from a specified template strand (Lane, B. Pace, Olsen, Stahl, Sogin, N. Pace, 1985). The template strand can be specified with specific primers (Lane, B. Pace, Olsen, Stahl, Sogin, N. Pace, 1985). The 16S ribosomal RNA gene is found in most microbes, and as a result amplifying this gene can lead to the identification of the microbe species that it came form (Lane, B. Pace, Olsen, Stahl, Sogin, N. Pace, 1985). Identifying the bacterial species from the transect will help us understand more about the bacteria that is growing in our ecosystem.
Materials and Methods:
Procedure 1
A 16S PCR amplification was performed during week 3. To recap, the PCR procedure was done to prepare for DNA sequencing. A single colony was transferred to 100 µl of water in a sterile tube. This was done 4 times, with 2 colonies from the nutrient plates and 2 colonies from the tetracycline plates. The 4 sterile tubes were incubated at 100˚C fir 19 minutes in a heat block. They were then centrifuged for 5 minutes at 13,400 rpm. While the tubes were being centrifuged, 20 µl of primer was added to a PCR tube. This was done for each colony. The PCR tubes were mixed to dissolve the PCR bead. After the centrifugation was complete, 5 µl of the supernatant was added to the PCR tubes. They were then placed in a PCR machine and left for a length of time. The following week the PCR product was run on an agarose gel. Two products were then selected for sequencing. The two tubes were then sent to a company to be sequenced.
Procedure 2
Several weeks later the sequences were returned and could be run through a BLAST search to identify the bacterial species. The two sequences that our groups was able to run were from the 10-7 nutrient agar plate and the 10-7 nutrient agar plus tetracycline plate. Online the sequences were obtained from the Genewiz online system. Then on the NIH's BLAST (Basic Local Alignment Search Tool) website a nucleotide blast was selected. The sequence for the 10-7 nutrient agar plate was then copied and pasted into the search box and a BLAST search was performed. This was then repeated with the 10-7 nutrient agar plus tetracycline plate. The results from the BLAST search were then compared with the observations made on the morphological characteristics of the bacterial colonies made during week 3.
Data and Observations:
When the PCR products were run on the agarose gel there were 3 of our 4 tubes that showed thick single bands (Figure 1). We chose to run 2 of these, 10-7 from the nutrient agar plate and 10-7 from the nutrient agar plus tetracycline plates to sequence.
The forward sequence identified from the 10-7 nutrient agar plate is:
NNNNNNNNNNNNNNCNNNNNNTGCAGTCGAGCGAATGGATTGAGAGCTTGCTCTCAAGAAGTTAGCGGCGGACGGGTGAG TAACACGTGGGTAACCTGCCCATAAGACTGGGATAACTCCGGGAAACCGGGGCTAATACCGGATAATATTTTGAACTGCA TGGTTCGAAATTGAAAGGCGGCTTCGGCTGTCACTTATGGATGGACCCGCGTCGCATTAGCTAGTTGGTGAGGTAACGGC TCACCAAGGCAACGATGCGTAGCCGACCTGAGAGGGTGATCGGCCACACTGGGACTGAGACACGGCCCAGACTCCTACGG GAGGCAGCAGTAGGGAATCTTCCGCAATGGACGAAAGTCTGACGGAGCAACGCCGCGTGAGTGATGAAGGCTTTCGGGTC GTAAAACTCTGTTGTTAGGGAAGAACAAGTGCTAGTTGAATAAGCTGGCACCTTGACGGTACCTAACCAGAAAGCCACGG CTAACTACGTGCCAGCAGCCGCGGTAATACGTAGGTGGCAAGCGTTATCCGGAATTATTGGGCGTAAAGCGCGCGCAGGT GGTTTCTTAAGTCTGATGTGAAAGCCCACGGCTCAACCGTGGAGGGTCATTGGAAACTGGGAGACTTGAGTGCAGAAGAG GAAAGTGGAATTCCATGTGTAGCGGTGAAATGCGTAGAGATATGGAGGAACACCAGTGGCGAAGGCGACTTTCTGGTCTG TAACTGACACTGAGGCGCGAAAGCGTGGGGAGCAAACAGGATTANATACCCTGGTAGTCCACNCCGTANCNATGANTGCT AANTGTTAGAGGGTTTCCGCCCTTTANTGCTGAANTTAACGCATTAAGCACTCCGCCTGGGGAGTACNGGCCNNNANGGC TGAANCTCAAANGAATTGACNGGGGCCCGCACNAGCGGTGGNANCATGTGGTTTAATTCNAANCANCGCNAANANCCTTN NCNNGTCGTGNCNTGCGTCNGAAAACCCTNANATNGGCTTCTNNNTCCGNAGCNNANTNGACNNNTGGTGCATGNTGTNN NNNTCNNNTCNNNNNATNTTGGNNNANTCNNNCANNNNNNCAACCNTGNNNTTNNNTGN
The forward sequence identified from the 10-7 nutrient agar plus tetracycline plate is:
NNNNNNNNNNNNNCNANNNATGCNAGCCGAGCGGTAGAGATTCTTCGGAATCTTGAGAGCGGCGTACGGGTGCGGAACAC GTGTGCAACCTGCCTTTATCAGGGGGATAGCCTTTCGAAAGGAAGATTAATACCCCATAATATATTGAATGGCATCATTT AATATTGAAAACTCCGGTGGATAGAGATGGGCACGCGCAAGATTAGATAGTTGGTGAGGTAACGGCTCACCAAGTCTACG ATCTTTAGGGGGCCTGAGAGGGTGATCCCCCACACTGGTACTGAGACACGGACCAGACTCCTACGGGAGGCAGCAGTGAG GAATATTGGACAATGGGTGCGAGCCTGATCCAGCCATCCCGCGTGAAGGACGACGGCCCTATGGGTTGTAAACTTCTTTT GTGTAGGGATAAACCTAGATACGTGTATCTAGCTGAAGGTACTATACGAATAAGCACCGGCTAACTCCGTGCCAGCAGCC GCGGTAATACGGAGGGTGCAAGCGTTATCCGGATTTATTGGGTTTAAAGGGTCCGTAGGCGGATTTGTAAGTCAGTGGTG AAATCTCACAGCTTAACTGTGAAACTGCCATTGATACTGCAAGTCTTGAGTGTTGTTGAAGTAGCTGGAATAAGTAGTGT AGCGGTGAAATGCATAGATATTACTTAGAACACCAATTGCGAAGGCAGGTTACTAAGCAACAACTGACNCTGATGGACGA AAGCGTGGGGAGCGAACAGGATTANATACCCTGGTNNTNNNNGCCGTNNCNATGCTAACTCNTTTTTGGAGCGCAANCTT CANAGACTAAGCGAAAGTGATAAGTTANCCACCTGGGGANTANNANCGCAAGTTTGAAACTCANAGGAATTGACGGGGGG CCCGCACAANCNGNTGGATTATGTNGTTTAATTCNATGATACGCGAGNANNCNGTACCNANGGCTTAANNGGGNAATNAC GGGGTNNANNAANNNACTTNTCTTNNACATTTTTNNANGTGCTNNANGGGTNNNTNNNTCNNCTCNTGCCCNTCAGNNNT ANGNTGANNTCCNNNNACNANNNNNNANCCCCTNNNCNNNNNNNCGATCNNNANGNNNNNGGNNNNCNNNNNNNNNNNNN CCTACGGNNNNNNNNN
The BLAST search identified the 10-7 nutrient agar colony as Bacillus cereus. The 10-7 nutrient agar plus tetracycline bacteria was identified as Chryseobacterium indologenes. The published characteristics of these two bacteria were then compared to the characteristics that we identified in week 3 (Table 1). For both colonies the morphological features that were identified in week 3 were the same as the colony morphology that was published. For the Bacillus cereus (10-7 nutrient agar plate), the correct cell shape (bacillus) was identified. However, it was identified as non-motile when it was motile, and was identified to not form chains or clusters when it does indeed form chains. It was correctly identified as gram positive. For the Chryseobacterium indologenes(10-7 nutrient agar plus tetracycline plate) the cell shape was identified as cocci when it is bacillus, but the fact that it was non-motile and formed clusters were both correctly identified. It was incorrectly identified as gram positive when it was in fact gram negative.
Conclusions and Future Directions:
Both of our amplified sequences were complete enough for us to identify the bacteria that they came from. The colony morphology was a complete match between our identification and published information about the Bacillus cereus and Chryseobacterium indologenes spp. However, for both bacteria we mis-identified certain cell characteristics, and we incorrectly identified Chryseobacterium indologenes as a gram positive bacterium when it if in fact gram negative. This could have been due to human error. It is possible that we did not correctly wash away all the crystal violet with the de-colorizer so that even if the violet did not penetrate the cells it could have been left on the slide itself, obscuring the view of the cells. If it were possible and we still have the agar plates we could repeat the gram stain in order to see if we were able to achieve a successful and accurate result. As it is, identifying the different bacteria species enabled us to learn more the bacteria inhabiting our ecosystem. Both Bacilllus cereus and Chryseobacterium indologenes are soil bacteria, which makes sense since they were isolated from a soil sample form the transect (Bottone, 2010; Vandamme, Bernardet, Segers, Kersters, Holmes, 1994). While Chryseobacterium indologenes is not usually isolated in humans (Vandamme, Bernardet, Segers, Kersters, Holmes, 1994), certain strains of Bacillus cereus can cause serious food-borne illnesses (Bottone, 2010).
References:
Bottone, E. J. 2010. Bacillus cereus, a Volatile Human Pathogen. Clinical Microbiology Reviews, 23(2): 382–398.
Lane, D.J., Pace, B., Olsen, G. J., Stahl, D. A., Sogin, M. L., Pace, R. N. 1985. Rapid determination of 16S ribosomal RNA sequences for phylogenetic analyses. Proceedings of the National Academy of Sciences of the United States of America, 82(20): 6955–6959.
Vandamme, P., Bernardet,J. F., Segers, P., Kerstersm K., Holmes, B. 1994. New Perspectives in the Classification of the Flavobacteria: Description of Chryseobacterium gen. nov., Bergeyella gen. nov., and Empedobacter norn. rev. International Journal of Systematic Bacteriology, 44(4): 827-831.
-SM
Invertebrates and Vertebrates
02/15/2015
Purpose:
When we think of life on earth the first group of organisms that comes to mind is often animals. This is understandable, of course, given that as humans we are animals, but the category animals is a lot more diverse than many think it is, and there are many subcategories which can also themselves be broken down further. One of the biggest divisions among animals is between invertebrates and vertebrates. Invertebrates include the phyla Porifera, Cnidaria, Ctenophora, Platyhelminths, Nematoda, Annelida, Rotifers, Mollusca, Arthropods, and others, for a total of 14 different phyla (Bentley, Walter-Conte, Zeller, 2015). Invertebrates can also be categorized by the development (or lack thereof) of their digestive tract. Acoelomates are organisms whose digestive system lacks a fluid filled cavity, called a coelom, which separates their digestive tract from the outer body wall (Bentley, Walter-Conte, Zeller, 2015). In comparison, pseudocoelomates have an incompletely lined coelom, and coelomates have a fully lined, fluid-filled coelom (Bentley, Walter-Conte, Zeller, 2015). Characterizing the invertebrates and vertebrates can help us to identify what species are present in the manicured grass transect, and will help us understand the relationship between different organisms.
Materials and Methods:
Procedure I
The acoelomate, Planaria, was observed with a dissecting scope. The digestion and the movement of the organism were observed. A cross-section of the Planaria was examined with the microscope to see the stained digestive tract. A nematode was then observed under a dissection scope and movement was recorded, and a cross-section was examined under the microscope to see the pseudocoelmate structure. Lastly the coelomate Annelida, or the earthworm, was observed, and again, movement was recorded.
Procedure II
In order to understand more about the class and orders of arthropods, which will be the most common phyla of invertebrates found in the transect, example organisms from each of the five major classes were examined. The 5 major classes are arachnida, diplopoda, chilopoda, insect, and crustacea.
Procedure III
Next the organisms from the Berlese Funnel were observed and categorized. The Funnel was carefully dismantled and the remaining leaf litter was discarded. The top 15 mLs of liquid and organisms was poured into a labeled Petri dish. The remaining liquid was poured into a second labeled petri dish. Both dishes were then examined with a dissecting microscope. All invertebrates that could be seen were identified by phylum and class. Their length in mm was measured, and the number that could be found in the sample was recorded.
Procedure IV
As a final step, the vertebrates that inhabit or pass through the transect were considered. When possible, either from observation of the vertebrate, its droppings, or its footprints, vertebrates confirmed to live in the transect were used. However, other organisms, that although not seen, that might inhabit the transect were also used. The vertebrates were classified from phylum through to species. Then, a food web was constructed based on all the groups of organisms that have been observed in the transect over the past month.
Data and Observations:
Procedure I
The Planaria moved in an crawling fashion, where it would scrunch up and then stretch out, inching along. In contrast the Nematoda seemed to glide more effortless. It did not scrunch up, but it could be observed moving back and forth to propel itself. The earthworm seemed to move in a similar fashion to the Planaria. It had a clearly segmented body, and it seemed to scrunch the segments together and then propel itself forward.
Procedure II
Organisms from the five major classes of the arthropods were examined. There was a crab from the class Crustacea, several spiders from the class Arachnida (Figure 1), a centipede from the class Chilopoda, a millipede from the class Diplopoda, and several different organisms from the class insect. There were also other on-arthropod invertebrates, including starfish, sand dollars, and a squid (Figure 2).
Procedure III
Five different invertebrates were identified from the Berlese Funnel. In the petri dish with the liquid from the top of the tube, several Springtails and a singular Thrips were discovered. In the petri dish with the remaining liquid, a Soil Mite, several Ants, and a Nematode Worm were observed. Their characteristics are summarized in Table 1.
Procedure V:
After several visits to the transect, the only vertebrate that had been observed was a ground squirrel. Four other vertebrates that are likely to live in a grassland habitat were also analyzed. Information on these vertebrates is summarized in Table 2. A food web was constructed based on these vertebrates, as well as all the other organisms classified over the course of the transect observation (Figure 3).
Conclusions and Future Directions:
Procedure I
The movement of the different types of invertebrates can be attributed to their structure. Planaria have large muscles under their epidermis, which they contract and relax creating the inching movement (Stringer, 1917). They are also able to glide smoothly by beating their cilia (Stringer, 1917), although this was not observed in the lab. Nematodes also have muscles under their epidermis, but they are longer and are aligned longitudinally, which prevent them from crawling or inching, and instead only allow it to move from side to side (Wennemann, Shanks, Smith, 2004). Like the Planaria, the earthworm moves by contracting and relaxing its muscles, however it is aided by the presence of the fluid in the coelom, which provides a substance for the muscles to work against (Reish, 2013).
Procedure IV
After the food web was made, it was possible to look at how the organisms found throughout the month in the transect relate to the ecological concepts of “community”, “carrying capacity”, and “trophic level”. The food web represents a community, or the different organisms within an ecosystem that interact with one another (Freeman, Allison, Quillin, 2014). It shows how the different organisms all interact in terms of the energy transfer from organism to organism. A food web is also a helpful way to characterize all of the different trophic levels in the ecosystem (Freeman, Allison, Quillin, 2014). When an organisms eats another it is gaining energy from that latter organism. Animals that belong to the same trophic level obtain energy from the same organism, or, in other words, they eat the same organisms (Freeman, Allison, Quillin, 2014). This can easily be seen in the food web, because the organisms that have arrows pointing towards them that originate at a common third organism belong to the same trophic level. Carrying capacity is the maximum amount of a species that can survive in a given ecosystem (Freeman, Allison, Quillin, 2014). By showing the organisms that other organisms gain energy from, the food web illustrates how each organism’s carrying capacity is dependent on the amount of the organism which it obtains energy from that is present in the ecosystem.
References:
“American Crow.” Wikipedia, The Free Encyclopedia. 29 Dec. 2014. Wikipedia. (15 Feb. 2015).
“American Robin.” Wikipedia, The Free Encyclopedia. 27 Jan. 2015. Wikipedia. (15 Feb. 2015).
Bentley, M., Walters-Conte, K., Zeller, N. 2015. A Laboratory Manual to Accompany General Biology II. American University Department of Biology: Washington, DC. 44-49.
“Eastern Gray Squirrel.” Wikipedia, The Free Encyclopedia. 31 Jan. 2015. Wikipedia. (15 Feb. 2015).
Freeman, S., Allison, L., & Quillin, K. 2014. Biological science (5th ed.). Pearson: Glenview, IL. 1150-1151.
“Lark Sparrow.” Wikipedia, The Free Encyclopedia. 19 July 2014. Wikipedia. (15 Feb. 2015).
Reish, D.J. “Annelid”. Encyclopedia Britannica. 18 Dec. 2013. Britannica. (15 Feb. 2014).
Stringer, C. “The Means of Locomotion in Planarians”. Proceedings of the National Academy of Sciences of the United States of America. 15 Dec. 1917. JSTOR. (15 Feb. 2015).
Wennemann, L., Shanks, C.H., Smith, K.A. “Movement of Entomopathogenic Nematodes in Soils of Fragaria spp.”. Communications in Agriculture and Applied Biological Sciences. 2004. National Institutes of Health. (15 Feb. 2015).
“White-footed Mouse.” Wikipedia, The Free Encyclopedia. 26 April 2014. Wikipedia. (15 Feb. 2015).
-SM
Plantae and Fungi
02/07/2015
Purpose:
Fungi and Plants, both members of the domain Eukarya, play incredibly important and complex roles in our ecosystem. Fungi are important decomposers in the environment (Bentley, Walters-Conte, Zeller, 2015). They break down dead plant matter and release carbon dioxide into the atmosphere, perpetuating the carbon cycle (Bentley, Walters-Conte, Zeller, 2015), and also release nitrogen into the soil and water. Plants, as the main photosynthesizers on the land (Freeman, Allison, Quillin, 2014), produce oxygen. Therefore, without plants humans would suffocate from a lack of oxygen (Freeman, Allison, Quillin, 2014). Whether it is by releasing carbon dioxide into the atmosphere or oxygen, both fungi and plants respectively are incredibly important parts of the ecosystem, and are therefore most likely present in our transect. Characterizing the plants and fungi can help us to identify what species are present in the manicured grass transect.
Materials and Methods:
Procedure I
First samples were collected from transect #5. A 500g leaf litter sample from an area with soft soil and dead leaves was collected to set up a Berlese funnel for collecting invertebrates. Then 5 representative samples from five different plants within the transect were collected.
Procedure II
Following the sample collection plant vascularization was studied. The stems of moss (a bryophyte) and a lily (an angiosperm) were examined under a 40x lens in order to see the difference between a plant with a vascular system and a plant without a vascular system. Then, after becoming more comfortable with observing vascular systems, the vascularization of the five plants collected from the transect was determined. In order to do this cross-sections from each plant were prepared and observed, and the height of each plant was measured.
Procedure III
After plant vascularization was determined, the plants were observed in order to determine if there were any specialized structures. First the leaves of the moss were examined with a dissecting scope. Then a cross-section of the lily leave was examined. The two were then compared to see if there were any visible specialized structures. Then the leaves of the five collected plants were examined. The shape, size, and cluster arrangement of the leaves was noted, and they were then observed under a 10x or 40x lens.
Procedure IV
Next the mechanisms of reproduction were observed. The moss was again examined. The male and female gametophytes were observed, as were the sporophytes. The lily flower was then dissected and the different parts of the flower’s reproductive system were identified. Finally the plants from the transect were determined to be either monocot or dicot through observation of any seeds that were found as well as the leaves.
Procedure V
Lastly fungi were observed. 3 different fungal samples were observed, one through a dissecting scope, and 2 others through a 40x lens. Through observation is was confirmed that they were indeed fungi, and then they were classified as belonging to either the Zygomycota group, the Basidiomycota group, and to Ascomycota group. Then a picture was drawn of one of the fungi.
Procedure VI
Finally the procedure for the following week, a Berlese Funnel to collect invertebrates, was set up. 25 mL of 50:50 ethanol/water solution was added to a 50 mL conical tube. Then a piece of screening tape was placed into the bottom of a funnel and secured with tape so that the leaf litter would not fall through. Then the leaf litter sample was added to the top of the funnel. The funnel was placed in a clamp attached to a ring stand. The funnel was then placed into the tube with the ethanol solution. The base of the funnel and the tube were then taped and parafilmed together so that the ethanol would not evaporate. A 40-watt lamp was then placed 1-2 inches from the top of the funnel. Everything was covered in foil and the funnel was left for one week.
Data and Observations:
Procedure I
The five plants collected from the transect were manicured grass (Figure 1), clover (Figure 2), spider grass (Figure 3), a rose bush (represented by the bud) (Figure 4), and a small flowering weed (Figure 5).
Figure 1
Figure 2
Figure 3
Figure 4
Figure 5
Procedure II-IV
After the morphological traits of the plants were observed they were recorded in Table 1. Table 1 also includes observations on vascularization, specialized structures, and mechanisms of reproduction. The morphological characteristics of the leaves of each plant are recorded in Table 2. Determinations of monocot or dicot labels for each plant are summarized in Table 3.
Procedure V
The three observed samples were all fungi. The first, seen under the dissecting scope, was a mushroom, which is a Basidiomycota. The second, which was a species in the Rhizopus genus and a part of the Zygomycota division, showed the mating of two hyphae and the formation of a zygosporangium (Figure 6). The formation of the zygosporangium indicates that it is indeed a fungus. The third was Rhizopus nigricans, or bread mold, which is again a member of the Zygomycota division (Figure 7).
Conclusions and Future Directions:
Collecting and observing the five types of plants was an effective demonstration of the three main characteristics that differentiate plants: vascularization, presence (or lack) of specialized structures, and mechanisms of reproduction. It also showed the incredible morphological diversity present in plants. The fact that all of the plants had vascular systems shows how, with the exception of mosses (which we did not find any of), almost all plants have vascularization. By examining the morphological characteristics of each plant it was possible to identify all five plants as angiosperms, or flowering plants. Although it can be hard to imagine grasses as flowering plants because they are so often cut short and maintained, they are also angiosperms (Braselton, 2013). Although no seeds of pinecones were found in the transect to dissect, the observations of the vascular system from cross-sections of the plants and the observations of the leaves allowed monocot and dicot classifications to be made. Next week we will be able to identify invertebrates from the transect with the Berlese funnel.
References:
Bentley, M., Walters-Conte, K., Zeller, N. 2015. A Laboratory Manual to Accompany General Biology II. American University Department of Biology: Washington, DC. 34-43.
Braselton, J.P. “The Flowering Plants”. Plasmodiophorid Home Page. 2013. Ohio University. (9 Feb. 2015) <http://www.ohio.edu/people/braselto/readings/angiosperms.html>
Freeman, S., Allison, L., & Quillin, K. 2014. Biological science (5th ed.). Pearson: Glenview, IL. 577-580.
-SM
Bacteria Morphology
01/30/2015
Purpose: The three domains of life are Bacteria, Archaea, and Eukarya (Freeman, Allison, Quillin, 2014). Prokaryotes, organisms without organized organelles and without nucleus-bound genetic material, make up the Bacteria and Archaea domains (Freeman, Allison, Quillin, 2014). Bacteria are most likely found in our transect, and thus will have grown into visible colonies on our agar plates. Archaea, however, which prefer extreme environments like hot springs (Bentley, Walters-Conte, Zeller, 2015), are probably not present in our transect, and thus will not have grown on our agar plates. The bacteria that have grown on the plate can be categorized by colony morphology and cell morphology. The colonies can be described in terms of color, texture, shape, edge, and elevation. The bacteria can be described in terms of shape (bacillus, or rod; cocci, or sphere; spirilum, or spiral (Bentley, Walters-Conte, Zeller, 2015)), motility, size, gram type, and arrangement. Characterizing the bacteria in these ways can help us to identify what bacteria species are present in the manicured grass transect.
Materials and Methods:
Procedure I
First the Hay Infusion Culture was observed one final time. Any changes were recorded. Then, the agar plates from last week were observed. The number of colonies on the 4 nutrient plates and the 4 tetracycline plates were counted, and then a conversion was done to account for the serial dilution that was performed the previous week and to find the number of colonies per mL. The conversion factor for the 10-3 plates was x 103, the conversion factor for the 10-5 plates was x105, the conversion factor for the 10-7 plates was x107, and the conversion factor for the 10-9 plates was x109.
Procedure II
Next, the nutrient agar plates were compared to the tetracycline plates in order to assess antibiotic insensitivity or resistance.
Procedure III
After this, wet mount slides were observed. 4 wet mount slides were made with 4 respective colonies, 2 from the nutrient plates and 2 from the tetracycline plates. A tiny amount of growth from the chosen colony was scraped from the plates with a sterilized loop, was dissolved into one drop of water on the slide, and then a cover slip was added. This was repeated for each of the 4 chosen colonies. The slides were carefully labeled to indicate which plate they came from. These were observed under a 40x and then a 100x oil immersion and the morphology, organization, and any modes of motility were documented for each colony. Lastly, a gram stain was performed. Again, a tiny amount of growth from the chosen colony was scraped from the plates with a sterilized loop and was dissolved into one drop of water on the slide. This was done for each of the 4 colonies, and again, the slides were carefully labeled. The slides were then passed through a flame, bacteria side up, in order to heat fix the smear. Then, after being placed in a staining tray, the slides were covered with crystal violet for 1 minute, and then rinsed with water. Then they were covered with Gram’s iodine for 1 minute, and then again rinsed. Then they were decolorized with 95% alcohol for 20 seconds, and then again rinsed. Finally they were covered with safranin for 30 seconds, and rinsed one last time. The slides were then observed under 40x and 100x oil immersion and it was recorded whether they were gram positive or negative.
Procedure IV
Lastly a PCR procedure was done to prepare for later DNA sequencing. A single colony was transferred to 100 µl of water in a sterile tube. This was done 4 times, with 2 colonies from the nutrient plates and 2 colonies from the tetracycline plates. The 4 sterile tubes were incubated at 100˚C fir 19 minutes in a heat block. They were then centrifuged for 5 minutes at 13,400 rpm. While the tubes were being centrifuged, 20 µl of primer was added to a PCR tube. This was done for each colony. The PCR tubes were mixed to dissolve the PCR bead. After the centrifugation was complete, 5 µl of the supernatant was added to the PCR tubes. They were then placed in a PCR machine and left for the following week.
Data and Observations:
Procedure I
When the Hay culture was observed for the last time there were several changes. The most obvious change was that a significant amount of the liquid had evaporated. A visible ring on the jar indicated the original water level (Figure 1). The film on top of the water was thinner than it had been the previous week, and it was no longer continuous. Instead it was only visible in some spots (Figure 2). The dirt was still settled on the bottom, and the culture still had the same strong smell. The most obvious changes were because of evaporation. It is possible that the film deteriorated because the bacteria or mold that it was made of began to die from a lack of nutrients. The results of observing and quantifying the colonies on the 8 agar plates are summarized in Table 1.
Procedure II
In general, there were a lot more colonies on the nutrient plates than the nutrient plus tetracycline plates at each dilution. There were a lot more white colonies on the nutrient agar plates than there were on the nutrient plus tetracycline plates, although, proportionally, this did not seem to be the case for the yellow colonies.
Procedure III
The first of the four colonies observed was from the nutrient 10-7 dilution (Figure 3). The second was from the nutrient 10-9 dilution (Figure 4). The third was from the nutrient plus tetracycline 10-5 dilution (Figure 5), and the fourth from the nutrient plus tetracycline 10-7 dilution (Figure 6). After the colonies were observed, wet mount slides were made and the morphological characteristics of the bacteria and their gram stain results were determined with a microscope. These results are described in Table 2. The wet slide made from colony #1 showed a gram-positive bacillus (Figure 7). The slide from colony #2 showed a gram-negative cocci (Figure 8). The slide of colony #3 showed a gram-positive coccibacillus (Figure 9). The slide from colony #4 showed a gram-positive cocci (Figure 10).
Conclusions and Future Directions:
Both the examination of the colonies, and the examination of the bacteria that make up the different colonies, demonstrated the vast variety of bacterial species from the transect. The sheer number of colonies present per mL is staggering, and it reveals how much life there is in our everyday environment that we cannot see in our day-to-day lives. The disproportionate decrease of the white colonies in the tetracycline plates indicates that the species of bacteria that forms these white colonies is affected by tetracycline, while the bacteria that form the yellow colonies may be either insensitive or resistant to tetracycline. Tetracycline, which can inhibit both gram-positive and gram-negative bacteria, operates by inhibiting protein synthesis (Chopra, Roberts, 2001). It does this by inhibiting the attachment of aminoacyl-tRNA to the ribosomal acceptor site (Chopra, Roberts, 2001). It is effective against the genera chlamydiae, mycoplasmas, and rickettsiae, and has also been found to be effective against Bacillus anthracis and Yersinia pestis (Chopra, Roberts, 2001). Looking at the bacteria under the microscope, especially with the oil immersion, revealed how, even if the colonies were morphologically similar, the bacteria themselves could be morphologically unique. Next week we will be able to sequence DNA from the PCR reaction in order to hopefully identify the bacterial species.
References:
Freeman, S., Allison, L., & Quillin, K. 2014. Biological science (5th ed.). Pearson: Glenview, IL. 531, 1174-1175. Bentley, M., Walters-Conte, K., Zeller, N. 2015. A Laboratory Manual to Accompany General Biology II. American University Department of Biology: Washington, DC. 26-27. Chopra, I., & Roberts, M. (2001). Tetracycline Antibiotics: Mode of Action, Applications, Molecular Biology, and Epidemiology of Bacterial Resistance. Microbiology and Molecular Biology Reviews. 65(2): 232-260.
-SM
Identifying the Algae and Protists of Transect #5
01/24/2015
Purpose:
The invention and perfection of microscopes has allowed scientists to discover and further their understanding of microscopic unicellular and multicellular organisms (Bentley, Walters-Conte, Zeller, 2015). These microscopic organisms, and all organisms, can be broken down into either prokaryotes or eukaryotes. Within eukaryotes, there are 2 main groups of unicellular organisms: algae and protists (Bentley, Walters-Conte, Zeller, 2015). If a sample from the Hay Infusion Culture is examined under a microscope, it can be predicted that both of these types of unicellular prokaryotes can be found living in the observed transect.
Materials and Methods:
Procedure I
The jar with the Hay Infusion Culture from the previous week was carefully brought over to the lab bench. The culture is considered an ecosystem with many different types of niches. Careful observations were made about the appearance and smell of the culture. Then, samples from 2 different niches ¬– the top film and the debris that had settled on the bottom – were taken for microscopic observation. Wet mounts were made from these samples, and then were observed under a 10x and then 40x microscope lens. Three different organisms were observed from each niche and were then identified using a dichotomous key. Pictures of the organisms were then drawn, and careful notes and measurements were taken.
Procedure II
After this was completed, prep work for the following lab was done. Four tubes, each containing 10 mLs of sterile broth, were obtained. The tubes were labeled 10-2, 10-4, 10-6, and 10-8. The four nutrient agar plates and four nutrient agar plus tetracycline plates (+tet) were obtained. One plate from each of these 2 sets of plates was labeled 10-3, 10-5, 10-7, and 10-9. The lid was placed on the Hay Infusion Culture and then it was swirled to mix the contents. Then, using a 100-microliter micropippeter, 100 µl of the culture was added to the broth tube marked 10-2. The tube was swirled. Then 100 µl from the 10-2 tube was added to the 10-4 tube. That tube was swirled, and then 100 µl from the 10-4 tube was added to the 10-6 tube. Again, the contents of that tube were swirled, and then 100 µl from the 10-6 tube were added to the 10-8 tube. Once these dilutions were complete, they were plated on the agar and agar plus tetracycline plates. 100 µL of the 10-2 dilution was pipetted onto the agar plate marked 10-3 and then 100 µl was pipetted onto the +tet plate marked 10-3. The sample was then spread on the respective plates. This procedure was then repeated four times, with the 10-4 dilution on the 10-5 agar and +tet plates, the 10-6 dilution on the 10-7 agar and +tet plates, and the 10-8 dilution on the 10-9 agar and +tet plates (Figure 1).
Figure 1
Data and Observations:
After sitting for one week, the culture was very different than it had been at the start. The culture seemed to have divided into different sections. All of the dirt had settled to the bottom. There were bits of mulch and vegetation floating in the middle. A thin, scab-like layer stretched across the culture on top of the liquid (Figure 2). This layer was mainly a light brown, although it had several large patches of a fuzzy looking white material, which was possibly mold (Figure 3).
Figure 2
Figure 3
There were no green shoots anywhere. The culture smelled terrible, with a bit of a rotting scent. 2 of the 3 organisms observed from the wet mount of the top of the culture were identified with the dichotomous key, while the 3rd remained a mystery. The first was clear, ovular, motile, about 60µm long, and had visible cilia and internal structures, as well as an indented oral groove (Figure 4). This was identified as the protozoan Colpidium.
The second was also clear, had an eggplant-esque shape, cilia, and was about 180 µm (Figure 5). This was identified as a paramecium protozoan.
The third one was not possible to identify with the given dichotomous key. It was clear, ovular, 110 µm long, and had cilia on both of the shorter ends (Figure 6).
Similarly, only 2 out of the 3 organisms from the wet mount of the bottom of the culture were identifiably with the dichotomous key. The 1st one was a very long oval, covered in cilia, 210 µm and moved in a corkscrew motion (Figure 7). It was identified as the protozoan Paramecium multimicronucleatum.
The 2nd one was also covered in cilia, and was ovular, but was a shorted oval shape – only about 80 µm long – and was a very dark green color, indicating that it carries out photosynthesis (Figure 8). It was identified as the protozoan Paramecium bursaria.
The 3rd one could not be identified with the provided dichotomous key. It was very small – only 10 µm long – was clear, spherical, and was constantly vibrating (Figure 9).
Conclusions and Future Directions:
All of the organisms that were identifiable with the dichotomous key were protozoa; we were not able to identify any algae. This does not necessarily mean that there were not any algae species living in the culture. Next time it may be better to make a wet-mount slide from the middle section of the culture, or to keep examining the wet mounts from the niches at the top and bottom of the culture to potentially identify any algae. The protozoa that were identified meet all the needs of life. For example, when looking at the Colpidium, the oral groove allows the organisms to eat, and therefore to obtain energy from, other organisms, meeting the first requirement of life (Freeman, Allison, Quillin, 2014). The organism is unicellular, and so the observable organism in itself meets the second requirement of being made up of membrane cells (Freeman, Allison, Quillin, 2014). The Colpidium was able to survive in the culture, even though it was not its normal or original environment. This demonstrates that the organism was able to process information about its environment and adjust to maintain a stable internal environment, and thus still survive in the culture, which meets the third need of life (Freeman, Allison, Quillin, 2014). The fourth requirement is replication. Although replication of the Colpidium was not directly observed, Colpidium has been observed to reproduce asexually through cysts (Cutler, Crump, 1924) thus meeting the fourth requirement. The last requirement of a living organism is that it is the product of evolution. Again, this is not something that was directly observable in the lab, but it is something that has been demonstrated over time (Cutler, Crump, 1924). Therefore, Colpidium meets all five needs of life. It is possible that if the culture had been left for a longer period of time than one week, such as, for example, two months, there would be differences. For example, Colpidium is often a source of food for various paramecium species (Cutler, Crump, 1924, so it is possible that there would be a lot less Colpidium organisms, because they would have been eaten, and a lot more paramecium species because they would have had a source of energy. This is also true of other species or organisms as well. Next week the agar and +tet plates will have hopefully grown bacteria cultures. We will be able to analyze these bacteria to identify different species present in transect #5.
References:
Cutler, D. W., Crump, L. M. 1924. The Rate of Reproduction in Artificial Culture of Colpidium colpoda. National Institutes of Health: Bethesda, MD.
Bentley, M., Walters-Conte, K., Zeller, N. 2015. A Laboratory Manual to Accompany General Biology II. American University Department of Biology: Washington, DC. 19-21.
Freeman, S., Allison, L., & Quillin, K. 2014. Biological science (5th ed.). Pearson: Glenview, IL. 2.
-SM
Observing a Transect
01/22/2015
Purpose
Life on Earth is incredibly diverse. While no one knows for certain how many different species exist, scientists predict that there are anywhere from 10 to 100 million different species (Freeman, Allison, Quillin, 2008). This incredible diversity can be represented on a small scale, in a contained ecosystem. An ecosystem, or transect, is a community that contains both biotic and abiotic components (Bentley, Walters-Conte, Zeller, 2015). One small 20 by 20 transect on the American University campus can be observed, and experimented on, in order to demonstrate the incredible diversity of life. If this is done, then it will be possible to observe the interrelation and complexity of species in several different niches within the same transect.
Materials and Methods
A triangular piece of land with 20-meter long sides was marked off. This land establishes the experimental transect (transect #5). The general characteristics of the transect were carefully observed and marked down in order to form a topographical map. Both biotic and abiotic components of the transect were carefully recorded. After thoroughly observing the transect, a sample of the soil and vegetation that was representative of the transect was collected in a 50 mL conical tube. This sample was then used to make a Hay Infusion Culture. This was done by removing 12 grams of the soil sample and adding it to a plastic jar. 500 mLs of deerpark water was then added to the jar, followed by 0.1 gm dried milk. With the lid placed on the jar, the solution was gently mixed. The top was then removed, and the jar was left to sit for one week.
Data and Observations
Transect #5 is situated in the “manicured grass” of the American University Eric Friedheim Quadrangle. The grass which dominates most of the transect is cut short, and clearly maintained. There are small patches of dirt and snow visible throughout the transect, and fallen leaves and acorns are scattered across the grass. There is also 2 pieces of visible trash on the grass, a straw and a fork. Along one side of the transect there is a slightly elevated, and clearly landscaped, mulch area. This mulch, which also has patches of dirt and snow, contains both deliberately planted (landscaped) and wild-growing plants. The landscaped plants include bushes with sharp thorns, which possibly resemble beach roses. There is also a different unidentified landscaped plant. There are several varieties of wild-growing plants, or weeds, as well, including dandelions, crabgrass/wild grass, and clover.
As the transect is an ecosystem, both biotic (living) and abiotic (nonliving) components present.
Biotic: Bushes with thorns (beach rose bushes?) Grass Berries Weeds (clover, dandelion, crabgrass) Worm Other landscaped plants
Abitoic: Snow Dirt Mulch Rocks Trash (straw, plastic fork)
After making detailed observations, an aerial-view topographical map of the transect was drawn. The red line represents the border of the transect.
Conclusions and Future Directions
A quick overview of the transect would probably lead to the conclusion that it is mainly grass, with some landscaped plants. However, by more closely observing the transect, it was possible to see a bit more of the diversity. It revealed that there were actually two separate kinds of landscaped plants, as well as some naturally growing weeds that were almost hidden by the beach rose bushes. It also revealed that there was mulch and partially melted snow mixed in with the dirt and grass. There were also pieces of trash hidden among the grass. This demonstrated how an ecosystem does in fact have both biotic and abiotic components. The complexity of the kinds of organisms within the transect was revealed through the closer observation. However, not all species of organisms were visible to the naked eye. In fact, about 1 teaspoon of soil can contain billions of microbes including unicellular eukaryotes and bacteria (Freeman, Allison, Quillin, 2008). By setting up the Hay Infusion Culture and letting it sit it will be possible to observe microscopic protists, algae, bacteria, and more, in the coming weeks.
References
Bentley, M., Walters-Conte, K., Zeller, N. 2015. A Laboratory Manual to Accompany General Biology II. American University Department of Biology: Washington, DC. 16. Freeman, S., Allison, L., & Quillin, K. 2014. Biological science (5th ed.). Pearson: Glenview, IL. 531, 1174-1175.
-SM
1/21/2015 OpenWetWare is successfully working. -SM